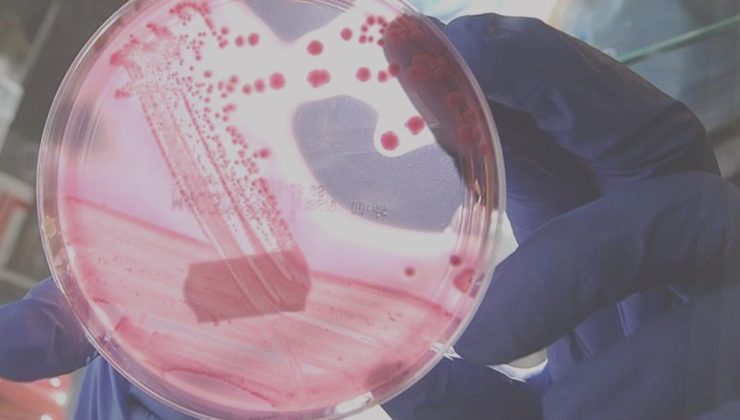
Erkeklerde en çok görülen ikinci kanser tipi aşikâr oldu

İzmir Katip Çelebi Üniversitesi (İKÇÜ) Atatürk Eğitim ve Araştırma Hastanesi Üroloji Anabilim Kolu Lideri Prof. Dr. Yiğit Akın, Sıhhat Bakanlığı istatistiklerine nazaran 100 bin bireyde her 2 ya da 3 bireyde bir prostat kanserini görebildiklerini belirterek, “Türkiye’de erkeklerde akciğer kanserinden sonra ikinci en sık görülen organ kanseri prostat kanseri” dedi.

İzmir Atatürk Eğitim ve Araştırma Hastanesi Üroloji Anabilim Kolu Lideri Prof. Dr. Yiğit Akın, 15 Eylül Dünya Prostat Kanseri Farkındalık Günü nedeniyle yaptığı açıklamada prostat kanserinin erkeklerde akciğer kanserinden sonra ikinci en sık görülen kanser çeşidi olduğunu tabir etti. Prostat kanserinin nedenlerinin hala tam olarak bilinemediğini anlatan Prof. Dr. Akın, “Hastalığın ortaya çıkmasında genetik-ailesel geçiş, çevresel faktörler ve beslenme şekli sorumlu tutulmaktadır. Birinci ve ikinci derece akrabalarında prostat kanseri olan erkeklerin, olmayanlara nazaran prostat kanserine yakalanma ihtimali 4 kat fazladır. Bu nedenle bu bireylerin 40 yaşından sonra her yıl üroloji uzmanına muayene olması gereklidir. Ağır metallere maruz kalanlar ve kimyasallarla çalışan şahıslarda de prostat kanseri ihtimali olağan topluma nazaran yüksektir. Son yıllarda tertipli hafif, orta antrenman ve Akdeniz tipi diyet de kanserden korunmada sıklıkla tercih ediliyor” dedi.
‘YILDA 1 SEFER DENETİME GİDİN’
Toplumda prostat kanseriyle ilgili farkındalığın hala tam olarak oluşmadığına vurgu yapan Prof. Dr. Yiğit Akın, şöyle devam etti:
“Sağlık Bakanlığı istatistiklerine göre ülkemizde erkeklerde akciğer kanserinden sonra ikinci en sık görülen organ kanseri prostat kanseridir. Kabaca bir istatistik değerlendirmede 100 bin şahısta her 2 yada 3 bireyde bir prostat kanserini görebiliyoruz. Sistemli doktor kontrolüne gitme halen toplumumuzda yerleşmedi. Halbuki prostat kanseri düzgün huylu prostat kanserinden farklı olarak hiçbir belirti vermeden ileri seviyeye ulaşabilir. Bu nedenle 45 yaşından büyük her erkek yılda 1 defa üroloji uzmanına muayene olmalıdır.”
‘3 DELİKTEN KAPALI AMELİYAT YAPIYORUZ’
Erken evre prostat kanserinde en uygun tedavinin cerrahi yollarla gerçekleştirilebildiğini belirten Prof. Dr. Akın, İzmir Atatürk Eğitim ve Araştırma Hastanesi Üroloji Kliniği olarak kapalı ameliyatları muvaffakiyetle gerçekleştirdiklerini lisana getirdi. Çok sayıda hasta kabul ettiklerini belirten Akın, “Prostat kanseri başlangıcında teşhis alan hastaların en güzel tedavisi cerrahidir. Yani radikal prostatektomi ameliyatıdır. Kliniğimizde uygun hastalara, 2017 yılında dünyada birinci kere yapılan ve hala devam eden yalnızca 3 delikten karın zarı içerisine girmeden kapalı prostat kanseri ameliyatı yapmaktayım. Bununla ilgili birçok akademik makale yurt dışı hakemli mecmualarda basıldı ve çok ilgi gördü. Yurt dışında toplantılara davetli cerrah olarak katıldım. 2024 yılında da ülkemizde ‘doctorsclub’ tarafından 130 bin üzerinde hekimin oyu ile yılın cerrahi seçildim. Şimdiye kadar bin 400 üzerinde hastaya şifa olduk, dahası da olur inşallah” diye konuştu.
HAFİF ANTRENMAN VE BESLENMEYE DİKKAT
Son olarak prostat kanserinin ülkede giderek artan sayıda teşhis aldığını anlatan Prof. Dr. Akın, “Bu nedenle 45 yaş üstü vatandaşların hiçbir şikayeti olmasa da yılda 1 defa üroloji uzmanına muayene olması ve serum prostat göstergesi (PSA) baktırmasını öneririz. Günlük aktivitelerine ek olarak 30 dakika hafif idman ve yağdan yoksul zerzevattan varlıklı diyet öneririz. Tedavi kısmında ise kesinlikle işin ehline tedavi için başvurmaları önemlidir” tabirlerini kullandı.
Bu haber, ilgili sitedeki gelişmelere dayalı olarak tekrar yazılmıştır.
🔸 Yepyeni içeriğin özünü koruyarak, özgünleştirilmiş halde sunulmuştur
 02:00
02:00

News
News


 Sağlık
Sağlık
 Sağlık
Sağlık
 Sağlık
Sağlık
 Sağlık
Sağlık
 Sağlık
Sağlık
 Sağlık
Sağlık







